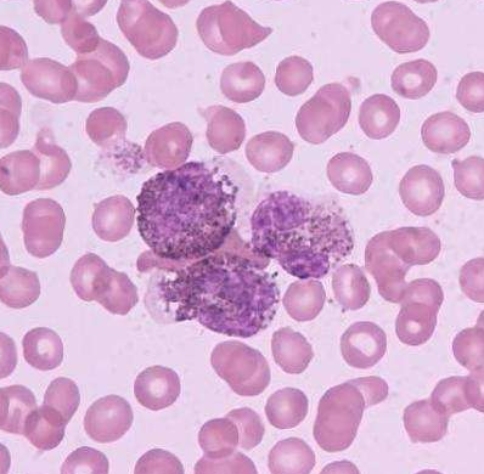

全球服務(wù)熱線:400-086-8008
美國兒童白血病治療 CAR-T治療方法生存期顯著延長
【本文為疾病百科知識,僅供閱讀】 2019-01-04 作者:厚樸方舟
CAR-T細(xì)胞治療方法方法方法方法方法方法是指通過對患者自身的癌癥殺傷細(xì)胞(T細(xì)胞)進(jìn)行基因工程改造,然后把經(jīng)過修飾過的T細(xì)胞重新回輸?shù)交颊唧w內(nèi)殺死癌細(xì)胞的治療方法。
臨床試驗結(jié)果是令人驚喜的:在接受tisagenlecleucel(Kymriah)的抗CD19 CAR-T治療方法的63例兒童中,83%的患者的腫瘤細(xì)胞在3個月時完全消除。
還記得美國孩子Emily Whitehead那激勵人心的故事嗎?
8年前她被診斷出急性淋巴細(xì)胞白血病,在經(jīng)歷了標(biāo)準(zhǔn)化療之后兩度復(fù)發(fā),在醫(yī)生們已經(jīng)無計可施、認(rèn)為好選擇臨終關(guān)懷時,父母沒有放棄,小Emily較終成了靠前位接受CAR-T新治療方法的兒童。
免疫細(xì)胞“特種兵”剿殺了她體內(nèi)的癌細(xì)胞,雖然經(jīng)歷了噩夢般的連續(xù)高燒,但Emily較終掙脫了死神的束縛?,F(xiàn)在,13歲的Emily正健康成長,她的體內(nèi)仍然能檢測到CAR-T抗癌細(xì)胞。
2018年4月,Emily Whitehead 基金會捐款給費城兒童醫(yī)院用于免疫治療方法方法方法方法方法研究
在這次ASH大會上,主要研究者、賓州大學(xué)兒童醫(yī)院的Stephan Grupp教授公布了研究的長期效果結(jié)果。
在這項名為ELIANA的,由25個國家參加的2期臨床試驗中,經(jīng)過24個月的隨訪,79名平均年齡在11歲的復(fù)發(fā)性或難治性急性淋巴細(xì)胞白血病患者接受單次tisagenlecleucel治療后,不會復(fù)發(fā)生存率為66%;12和18個月總生存率分別為76%和70%,獲得緩解的患者仍在繼續(xù)隨訪中。
Grupp教授對這項研究的結(jié)果感到興奮:
“這些患者入組時都是無法進(jìn)行移植或移植后白血病復(fù)發(fā),沒有更好的治療方案可用,而CAR-T治療使他們的病情得到緩解并持續(xù)有效?!?/p>
他認(rèn)為,微小殘留病變陰性與緩解持續(xù)時間和總生存期延長密切相關(guān),說明它在疾病長期控制方面具有良好潛力。除了早期發(fā)生的細(xì)胞因子釋放綜合征等主要不良反應(yīng)外,未發(fā)現(xiàn)新的毒性反應(yīng)。
盡管如此,如何維持患者的長期緩解仍然面臨挑戰(zhàn)。在此次大會上,很多學(xué)者分享了應(yīng)對復(fù)發(fā)的研究結(jié)果。
免疫檢查點抑制劑
針對免疫檢查點已有數(shù)款重磅藥物出現(xiàn),它們通過調(diào)節(jié)自身免疫系統(tǒng),讓免疫細(xì)胞主動殺傷癌細(xì)胞,不僅有更為廣泛的適應(yīng)癥,與化療藥物相比,也減少了副作用。
2018年諾貝爾生理學(xué)或醫(yī)學(xué)獎,也由此授予了兩位腫瘤免疫領(lǐng)域的先驅(qū)。
免疫檢查點抑制劑對血液腫瘤的治效果果如何?費城兒童醫(yī)院牽頭,將免疫檢查點抑制劑用于CAR-T治療后復(fù)發(fā)的急性淋巴細(xì)胞性白血病,研究證明這兩種治療方法有協(xié)同作用。
在給CAR-T治療后復(fù)發(fā)的患者使用pembrolizumab(K藥)或nivolumab(O藥)后,患者再次出現(xiàn)了不同程度的緩解。
此外,研究人員發(fā)現(xiàn),復(fù)發(fā)主要是由于CAR-T細(xì)胞的活力消失,其原因可能是受到的抗原刺激減少。
鑒于這個假設(shè),西雅圖兒童醫(yī)院對這部分患者用改造過的抗原表達(dá)T細(xì)胞定期回輸,以刺激CAR-T細(xì)胞功能的持久性,結(jié)果已初現(xiàn)效果,且不受威脅性高。
在CAR-T治療后復(fù)發(fā)的患者中發(fā)現(xiàn),造血干細(xì)胞移植也可以降低CAR-T細(xì)胞治療方法方法方法方法方法后的長期復(fù)發(fā)風(fēng)險。
CAR-T治療方法對成年人的復(fù)發(fā)性或難治性非何杰金氏淋巴瘤已經(jīng)證明不受威脅有效,但是,在一項針對兒童的2期臨床試驗中,CAR-T治療方法顯現(xiàn)出早期緩解,但持久性不如人意的結(jié)果,這可能與兒童和成年人淋巴瘤的免疫特征不同有關(guān)。
除了令人鼓舞的效果數(shù)據(jù),CAR-T治療方法的副作用也不容輕視。伴有細(xì)胞因子釋放綜合征的近一半患者需要重癥監(jiān)護(hù),40%的患者出現(xiàn)神經(jīng)系統(tǒng)不良事件。
盡管如此,研究者依然認(rèn)為,CAR-T治療方法讓血液腫瘤有了全新的治療方法,對于移植后復(fù)發(fā)或治療失敗的患者來說,這項治療給他們帶來了新的希望。同時也促使研究人員找出更合理的聯(lián)合治療方法來擴大它所帶來的益處。
目前,國內(nèi)也已經(jīng)有多家研究機構(gòu)在開展CAR-T治療方法的研究,相信不久的將來會有更多患者在CAR-T治療中獲益。
兒童急性白血病基因治療取得了令人矚目的進(jìn)展,如何在真實臨床實踐中更好地應(yīng)用需要集體智慧。
由美國13家主要的兒童腫瘤中心參加的兒童白血病臨床基因組研究,報告了對復(fù)發(fā)性、難治性以及高風(fēng)險白血病患者協(xié)作開展的基因檢測、生物指標(biāo)預(yù)后評判、靶向治療方案介紹等臨床經(jīng)驗,為今后更精準(zhǔn)的基因治療、藥物研發(fā)提供有益數(shù)據(jù)。
厚樸方舟2012年進(jìn)入海外醫(yī)療領(lǐng)域,總部位于北京,建立了由全球權(quán)威醫(yī)學(xué)專家組成的美日名醫(yī)集團(tuán),初個擁有日本政府官方頒發(fā)的海外醫(yī)療資格的企業(yè)。如果您有海外就醫(yī)的需要,請撥打免費熱線400-086-8008進(jìn)行咨詢!
本文由厚樸方舟編譯,版權(quán)歸厚樸方舟所有,轉(zhuǎn)載或引用本網(wǎng)版權(quán)所有之內(nèi)容須注明"轉(zhuǎn)自厚樸方舟官網(wǎng)(m.wyaoyao.cn)"字樣,對不遵守本聲明或其他違法、惡意使用本網(wǎng)內(nèi)容者,本網(wǎng)保留追究其法律責(zé)任的權(quán)利。
上一篇:美國看?。禾剿骼肨ALEN基因組編輯治療心血管疾病 下一篇:美國治療乳腺癌 探索乳腺癌躲避免疫系統(tǒng)監(jiān)視機制
熱門服務(wù)
推薦閱讀
美國權(quán)威醫(yī)學(xué)專家


服務(wù)案例更多>
全球咨詢服務(wù)熱線
400-086-8008
English | 微信端

互聯(lián)網(wǎng)藥品信息服務(wù)資格證書編號:(京)·非經(jīng)營性·2015·0179
厚樸方舟健康管理(北京)有限公司 版權(quán)所有 m.wyaoyao.cn
京ICP備15061794號
京公網(wǎng)安備 11010502027115號